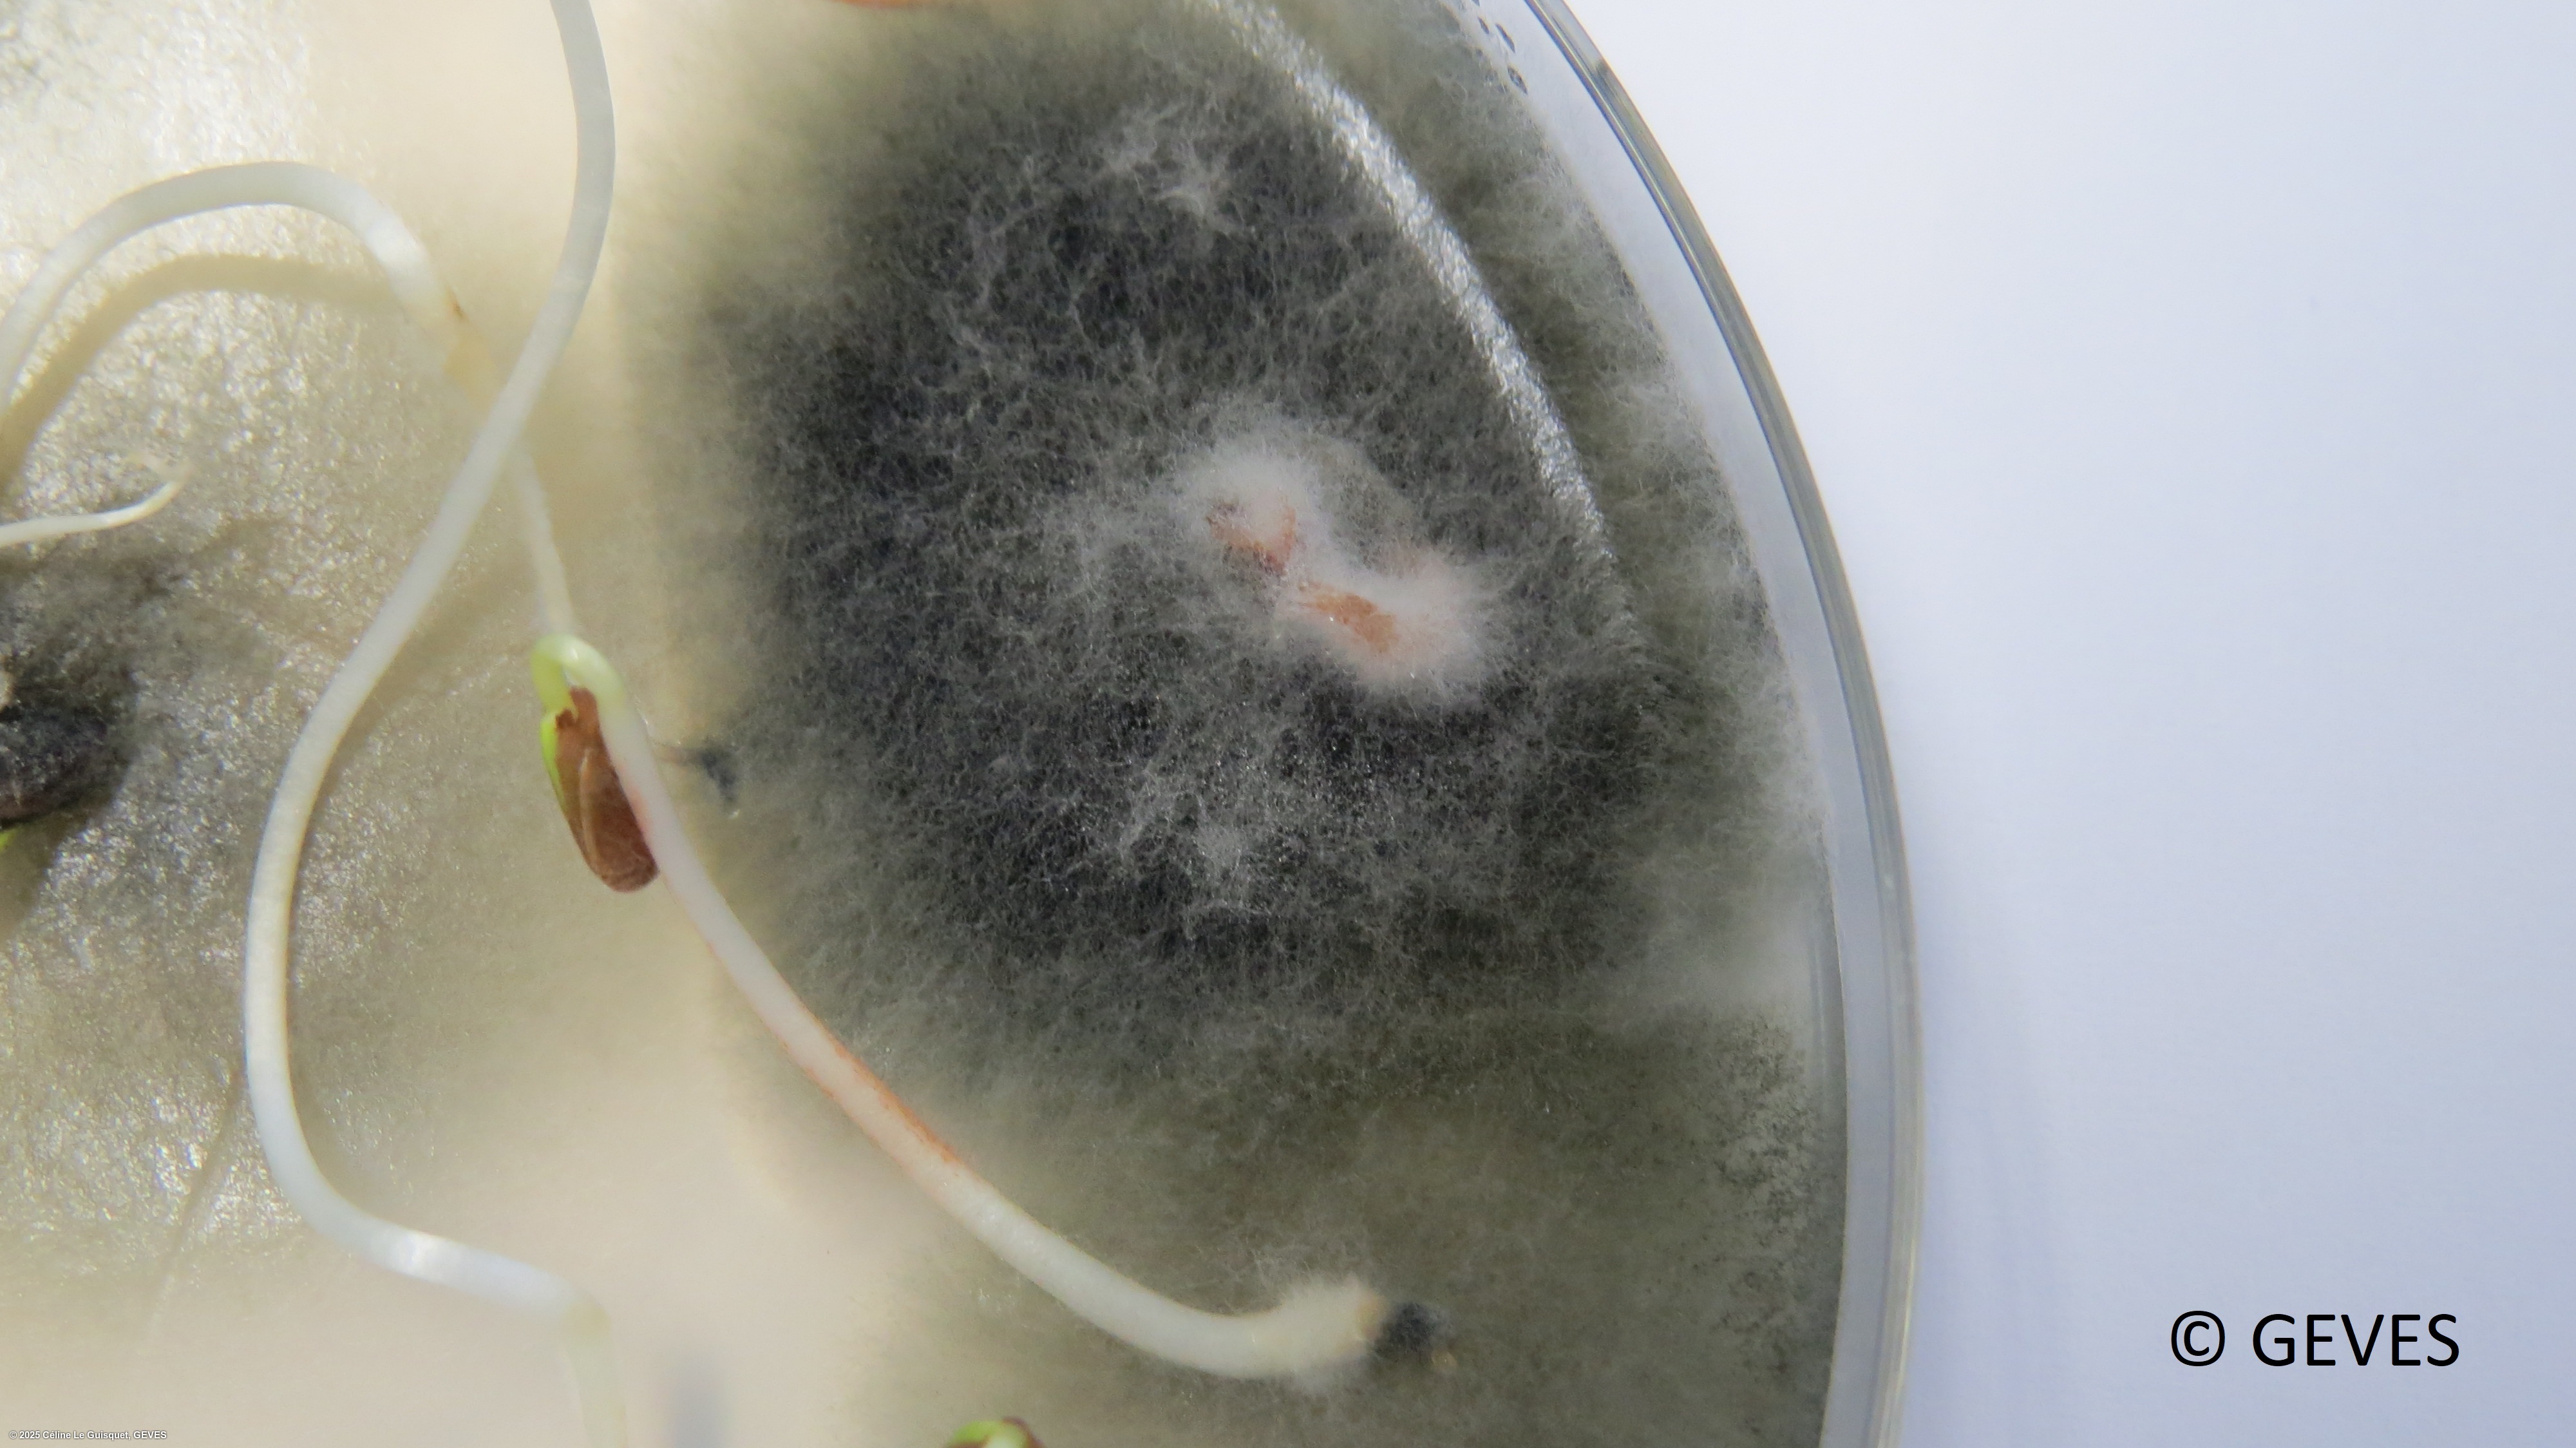
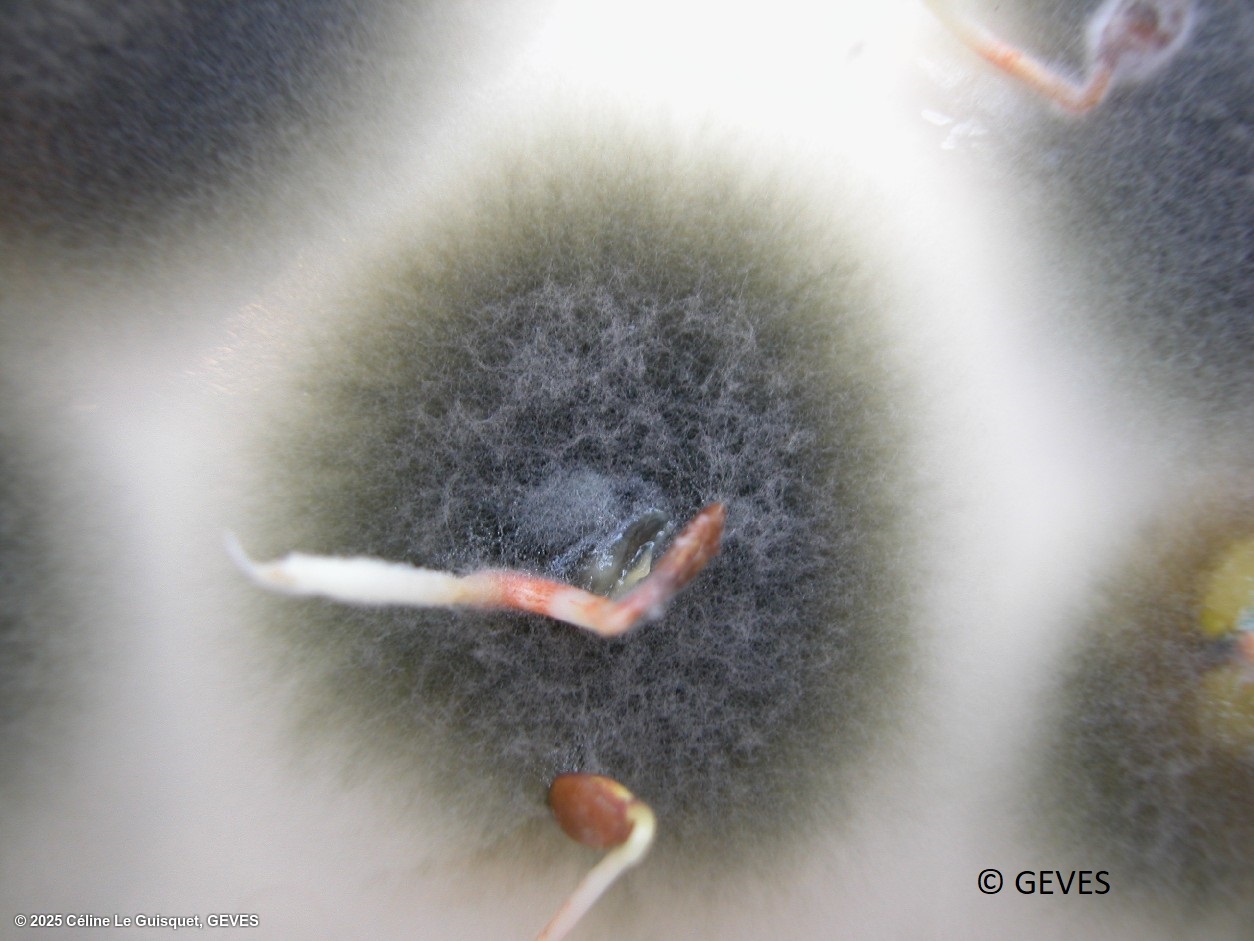

Alternaria linicola
Overview
|
Scientific name
|
Alternaria linicola |
|
Genus
|
Alternaria |
|
EPPO code
|
ALTELI |
|
Common name
|
Seedling blight |
|
Synonyms
|
|
Description
ISTA method 7-017, on malt agar. After 9 days of growth in appropriate chamber, examine plates for dense olive-grey colonies, 1.5-3cm in diamter. Some colonies of saprophytic Alternaria spp. can resemble those of A. linicola, but the conidia of A. linicola are diagnostic. Colonies should therefore be examined under x50-100 magnification. Conidiophores are simple, occuring singly or in bundles, unbranched, erect, often geniculate, with 1-2 or more scars, pale olive-brown and septate. Conidia form singly, are smooth walled, olive-brown, elongated conical to ellipsoid or obclavate, gradually tapering towards the beak. The beak is long, occasionally branched, muriform 4-16 μm with transverse septa and occasionally 1-4 longitudinal septa, sometimes slightly constricted at the septa, 16-230 x 3-4.5 μm (Corlett & Corlett, 1999; David, 1991; Malone & Muskett, 1997). The size of conidia (body and beak) is given as an indication but should not be a compulsory idnetification criteria. Size of conidia depends on the growth media, isolate, growth conditions; depending on refernces they have been described as (13-) 15-18 (-22.5) x (3-) 3.5-4 (-4.5) μm (Damm et al, 2014), or 20-130 x (7-) 17-24 (-30) μm (anonymous, 1991). Short red streak and water soaked areas may be visible on the hypocotyls and cotyledons of some infected seedlings.